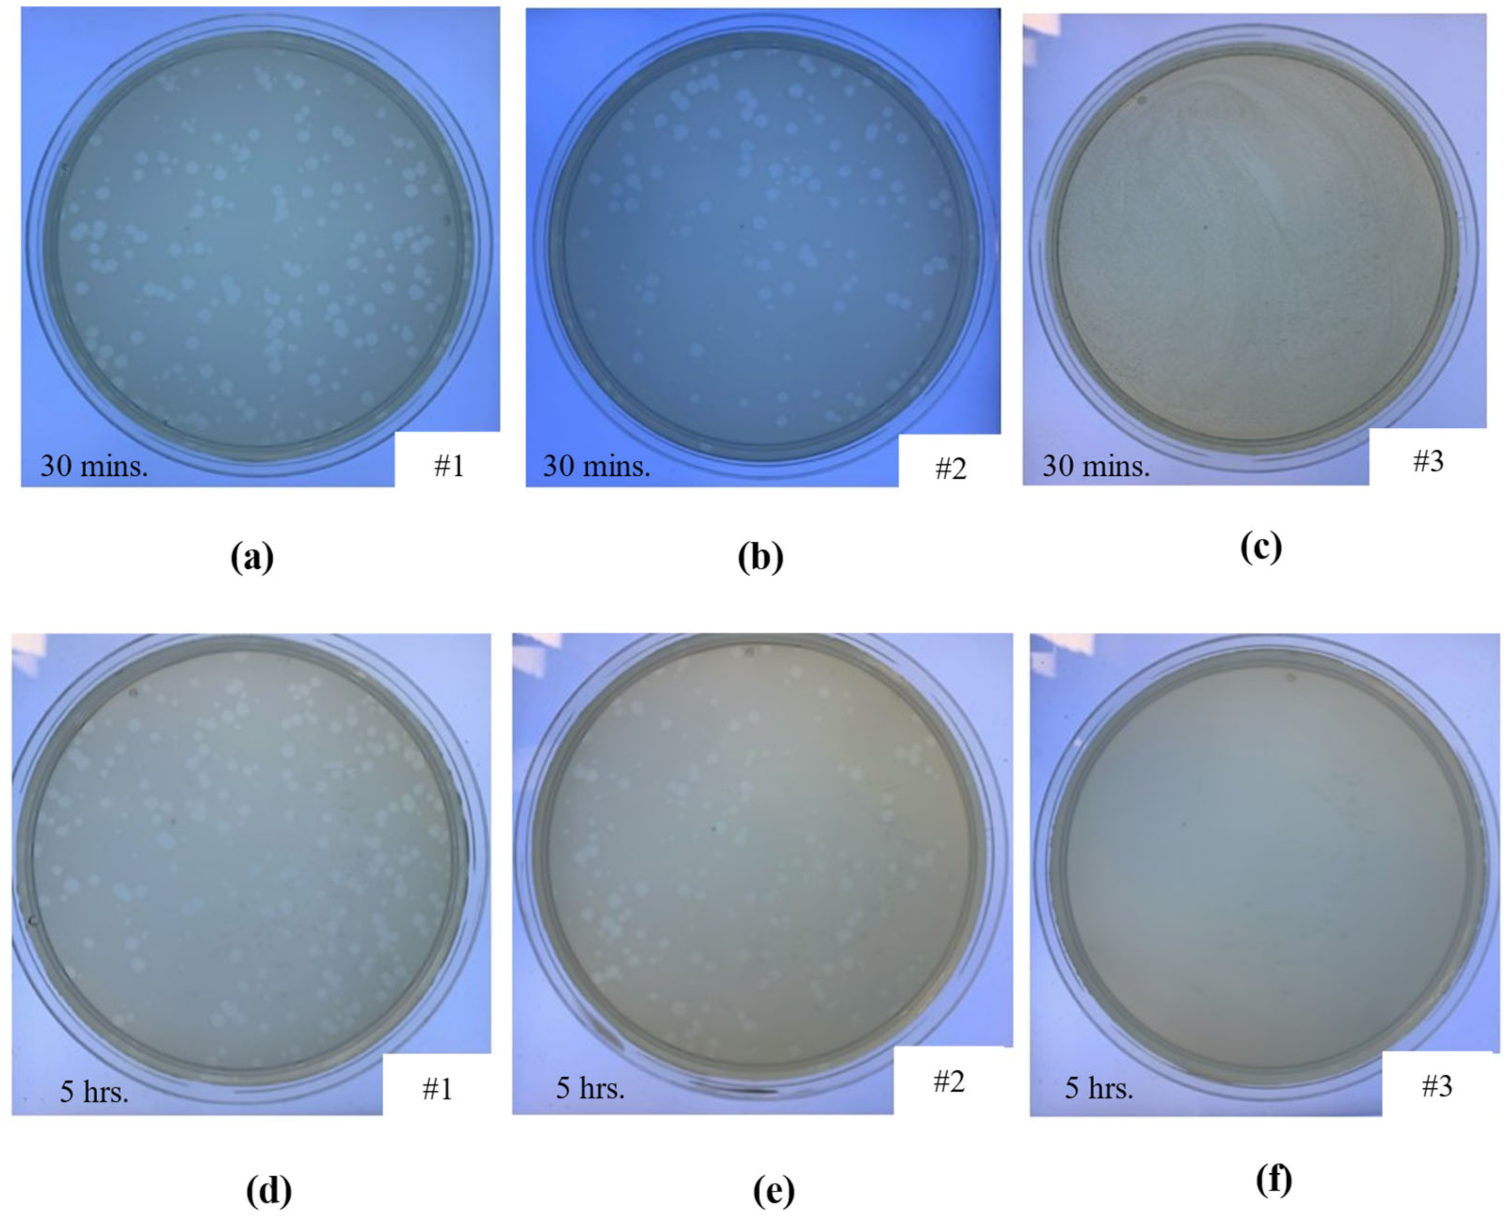
Ijms 22 12721 g010 550

3D Printed Cobalt-Chromium-Molybdenum Porous Superalloy with Superior Antiviral Activity
Abstract
:1. Introduction
2. Results and Discussion
2.1. Morphology LPBF Samples
2.2. Surrogate Model
2.2.1. Training Matrix and Regression Analysis
2.2.2. Model Accuracy
2.3. Significance of Individual Process Parameters
2.3.1. Laser Power
2.3.2. Scanning Rate
2.3.3. Hatch Spacing
2.4. Interaction Effects between LPBF Process Parameters
2.4.1. Track Thickness
2.4.2. Pore Diameter
2.5. Multi-Objective Optimisation
2.5.1. Predicting Optimal Solution
2.5.2. Fabrication and Validation of the Optimised Co-Cr-Mo Architecture
2.6. Antiviral Characterisation
3. Materials and Methods
3.1. Laser Powder Bed Fusion (LPBF)
3.2. Surrogate Modelling
3.3. Antiviral Characterisation
4. Conclusions
Author Contributions
Funding
Institutional Review Board Statement
Informed Consent Statement
Data Availability Statement
Acknowledgments
Conflicts of Interest
References
- Corman, V.M.; Muth, D.; Niemeyer, D.; Drosten, C. Hosts and Sources of Endemic Human Coronaviruses. Adv. Virus Res. 2018, 100, 163–188. [Google Scholar] [PubMed]
- Yang, X.; Yu, Y.; Xu, J.; Shu, H.; Xia, J.; Liu, H.; Wu, Y.; Zhang, L.; Yu, Z.; Fang, M.; et al. Clinical course and outcomes of critically ill patients with SARS-CoV-2 pneumonia in Wuhan, China: A single-centered, retrospective, observational study. Lancet Respir. Med. 2020, 8, 475–481. [Google Scholar] [CrossRef] [Green Version]
- Hassan, S.S.; Attrish, D.; Ghosh, S.; Choudhury, P.P.; Uversky, V.N.; Aljabali, A.A.A.; Lundstrom, K.; Uhal, B.D.; Rezaei, N.; Seyran, M.; et al. Notable sequence homology of the ORF10 protein introspects the architecture of SARS-CoV-2. Int. J. Biol. Macromol. 2021, 181, 801–809. [Google Scholar] [CrossRef] [PubMed]
- Hassan, S.S.; Aljabali, A.A.A.; Panda, P.K.; Ghosh, S.; Attrish, D.; Choudhury, P.P.; Seyran, M.; Pizzol, D.; Adadi, P.; Abd El-Aziz, T.M.; et al. A unique view of SARS-COV-2 through the lens of ORF8 protein. Comput. Biol. Med. 2021, 133, 104380. [Google Scholar] [CrossRef] [PubMed]
- Vellingiri, B.; Jayaramayya, K.; Iyer, M.; Narayanasamy, A.; Govindasamy, V.; Giridharan, B.; Ganesan, S.; Venugopal, A.; Venkatesan, D.; Ganesan, H.; et al. COVID-19: A promising cure for the global panic. Sci. Total Environ. 2020, 725, 138277. [Google Scholar] [CrossRef]
- American Lung Association. Learn About Pneumonia; American Lung Association: Chicago, IL, USA, 2020. [Google Scholar]
- Singhal, T. A Review of Coronavirus Disease-2019 (COVID-19). Indian J. Pediatr. 2020, 87, 281–286. [Google Scholar] [CrossRef] [PubMed] [Green Version]
- Bai, Y.; Yao, L.; Wei, T.; Tian, F.; Jin, D.Y.; Chen, L.; Wang, M. Presumed Asymptomatic Carrier Transmission of COVID-19. JAMA J. Am. Med. Assoc. 2020, 323, 1406–1407. [Google Scholar] [CrossRef] [PubMed] [Green Version]
- Wang, L.; Didelot, X.; Yang, J.; Wong, G.; Shi, Y.; Liu, W.; Gao, G.F.; Bi, Y. Inference of person-to-person transmission of COVID-19 reveals hidden super-spreading events during the early outbreak phase. Nat. Commun. 2020, 11, 1–6. [Google Scholar] [CrossRef] [PubMed]
- Liu, Y.; Ning, Z.; Chen, Y.; Guo, M.; Liu, Y.; Gali, N.K.; Sun, L.; Duan, Y.; Cai, J.; Westerdahl, D.; et al. Aerodynamic analysis of SARS-CoV-2 in two Wuhan hospitals. Nature 2020, 582, 557–560. [Google Scholar] [CrossRef]
- Richard, M.; Kok, A.; de Meulder, D.; Bestebroer, T.M.; Lamers, M.M.; Okba, N.M.A.; Fentener van Vlissingen, M.; Rockx, B.; Haagmans, B.L.; Koopmans, M.P.G.; et al. SARS-CoV-2 is transmitted via contact and via the air between ferrets. Nat. Commun. 2020, 11, 1–6. [Google Scholar] [CrossRef] [PubMed]
- Morawska, L.; Cao, J. Airborne transmission of SARS-CoV-2: The world should face the reality. Environ. Int. 2020, 139, 105730. [Google Scholar] [CrossRef] [PubMed]
- Wu, Y.; Guo, C.; Tang, L.; Hong, Z.; Zhou, J.; Dong, X.; Yin, H.; Xiao, Q.; Tang, Y.; Qu, X.; et al. Prolonged presence of SARS-CoV-2 viral RNA in faecal samples. Lancet Gastroenterol. Hepatol. 2020, 5, 434–435. [Google Scholar] [CrossRef]
- Seyran, M.; Takayama, K.; Uversky, V.N.; Lundstrom, K.; Palù, G.; Sherchan, S.P.; Attrish, D.; Rezaei, N.; Aljabali, A.A.A.; Ghosh, S.; et al. The structural basis of accelerated host cell entry by SARS-CoV-2. FEBS J. 2020, 288, 5010–5020. [Google Scholar] [CrossRef]
- Hassan, S.S.; Ghosh, S.; Attrish, D.; Choudhury, P.P.; Aljabali, A.A.A.; Uhal, B.D.; Lundstrom, K.; Rezaei, N.; Uversky, V.N.; Seyran, M.; et al. Possible Transmission Flow of SARS-CoV-2 Based on ACE2 Features. Molecules 2020, 25, 5906. [Google Scholar] [CrossRef] [PubMed]
- Baltimore, D. Expression of animal virus genomes. Bacteriol. Rev. 1971, 35, 235–241. [Google Scholar] [CrossRef] [PubMed]
- Zelikin, A.N.; Stellacci, F. Broad-Spectrum Antiviral Agents Based on Multivalent Inhibitors of Viral Infectivity. Adv. Healthc. Mater. 2021, 10, 2001433. [Google Scholar] [CrossRef] [PubMed]
- Ruiz-Hitzky, E.; Darder, M.; Wicklein, B.; Ruiz-Garcia, C.; Martín-Sampedro, R.; del Real, G.; Aranda, P. Nanotechnology Responses to COVID-19. Adv. Healthc. Mater. 2020, 9, 2000979. [Google Scholar] [CrossRef] [PubMed]
- Ho, W.; Gao, M.; Li, F.; Li, Z.; Zhang, X.Q.; Xu, X. Next-Generation Vaccines: Nanoparticle-Mediated DNA and mRNA Delivery. Adv. Healthc. Mater. 2021, 10, 2001812. [Google Scholar] [CrossRef] [PubMed]
- Mehta, A.; Michler, T.; Merkel, O.M. siRNA Therapeutics against Respiratory Viral Infections—What Have We Learned for Potential COVID-19 Therapies? Adv. Healthc. Mater. 2021, 10, 2001650. [Google Scholar] [CrossRef]
- Dobrowolski, C.; Paunovska, K.; Hatit, M.Z.C.; Lokugamage, M.P.; Dahlman, J.E. Therapeutic RNA Delivery for COVID and Other Diseases. Adv. Healthc. Mater. 2021, 10, 2002022. [Google Scholar] [CrossRef]
- Vu, M.N.; Kelly, H.G.; Tan, H.X.; Juno, J.A.; Esterbauer, R.; Davis, T.P.; Truong, N.P.; Wheatley, A.K.; Kent, S.J. Hemagglutinin Functionalized Liposomal Vaccines Enhance Germinal Center and Follicular Helper T Cell Immunity. Adv. Healthc. Mater. 2021, 10, 2002142. [Google Scholar] [CrossRef]
- Xiao, Y.; Torok, M.E. Taking the right measures to control COVID-19. Lancet Infect. Dis. 2020, 20, 523–524. [Google Scholar] [CrossRef] [Green Version]
- Tuñón-Molina, A.; Takayama, K.; Redwan, E.M.; Uversky, V.N.; Andrés, J.; Serrano-Aroca, Á. Protective Face Masks: Current Status and Future Trends. ACS Appl. Mater. Interfaces 2021. [Google Scholar] [CrossRef] [PubMed]
- Chin, A.W.H.; Chu, J.T.S.; Perera, M.R.A.; Hui, K.P.Y.; Yen, H.-L.; Chan, M.C.W.; Peiris, M.; Poon, L.L.M. Stability of SARS-CoV-2 in different environmental conditions. Lancet Microbe 2020, 1, e10. [Google Scholar] [CrossRef]
- Martí, M.; Tuñón-Molina, A.; Aachmann, F.L.; Muramoto, Y.; Noda, T.; Takayama, K.; Serrano-Aroca, Á. Protective Face Mask Filter Capable of Inactivating SARS-CoV-2, and Methicillin-Resistant Staphylococcus aureus and Staphylococcus epidermidis. Polymers 2021, 13, 207. [Google Scholar] [CrossRef] [PubMed]
- Tuñón-Molina, A.; Martí, M.; Muramoto, Y.; Noda, T.; Takayama, K.; Serrano-Aroca, Á. Antimicrobial Face Shield: Next Generation of Facial Protective Equipment against SARS-CoV-2 and Multidrug-Resistant Bacteria. Int. J. Mol. Sci. 2021, 22, 9518. [Google Scholar] [CrossRef]
- Cano-Vicent, A.; Tuñón-Molina, A.; Martí, M.; Muramoto, Y.; Noda, T.; Takayama, K.; Serrano-Aroca, Á. Antiviral face mask functionalized with solidified hand soap: Low-cost infection prevention clothing against enveloped viruses such as SARS-CoV-2. ACS Omega 2021, 6, 23495–23503. [Google Scholar] [CrossRef] [PubMed]
- Serrano-Aroca, Á.; Takayama, K.; Tuñón-Molina, A.; Seyran, M.; Hassan, S.S.; Pal Choudhury, P.; Uversky, V.N.; Lundstrom, K.; Adadi, P.; Palù, G.; et al. Carbon-Based Nanomaterials: Promising Antiviral Agents to Combat COVID-19 in the Microbial-Resistant Era. ACS Nano 2021, 15, 8069–8086. [Google Scholar] [CrossRef]
- Sanmartín-Santos, I.; Gandía-Llop, S.; Salesa, B.; Martí, M.; Lillelund Aachmann, F.; Serrano-Aroca, Á. Enhancement of Antimicrobial Activity of Alginate Films with a Low Amount of Carbon Nanofibers (0.1% w/w). Appl. Sci. 2021, 11, 2311. [Google Scholar] [CrossRef]
- Serrano-Aroca, Á.; Ferrandis-Montesinos, M.; Wang, R. Antiviral Properties of Alginate-Based Biomaterials: Promising Antiviral Agents against SARS-CoV-2. ACS Appl. Bio Mater. 2021, 4, 5897–5907. [Google Scholar] [CrossRef]
- Luganini, A.; Terlizzi, M.E.; Catucci, G.; Gilardi, G.; Maffei, M.E.; Gribaudo, G. The cranberry extract oximacro® exerts in vitro virucidal activity against influenza virus by interfering with hemagglutinin. Front. Microbiol. 2018, 9, 1826. [Google Scholar] [CrossRef] [PubMed]
- Walls, A.C.; Park, Y.J.; Tortorici, M.A.; Wall, A.; McGuire, A.T.; Veesler, D. Structure, Function, and Antigenicity of the SARS-CoV-2 Spike Glycoprotein. Cell 2020, 181, 281–292.e6. [Google Scholar] [CrossRef]
- Su, I.C.; Lee, K.L.; Liu, H.Y.; Chuang, H.C.; Chen, L.Y.; Lee, Y.J. Severe community-acquired pneumonia due to Pseudomonas aeruginosa coinfection in an influenza A(H1N1)pdm09 patient. J. Microbiol. Immunol. Infect. 2019, 52, 365–366. [Google Scholar] [CrossRef] [PubMed]
- Chou, C.C.; Shen, C.F.; Chen, S.J.; Chen, H.M.; Wang, Y.C.; Chang, W.S.; Chang, Y.T.; Chen, W.Y.; Huang, C.Y.; Kuo, C.C.; et al. Recommendations and guidelines for the treatment of pneumonia in Taiwan. J. Microbiol. Immunol. Infect. 2019, 52, 172–199. [Google Scholar] [CrossRef] [PubMed]
- Lee, J.Y.; Yang, P.C.; Chang, C.; Lin, I.T.; Ko, W.C.; Cia, C.T. Community-acquired adenoviral and pneumococcal pneumonia complicated by pulmonary aspergillosis in an immunocompetent adult. J. Microbiol. Immunol. Infect. 2019, 52, 838–839. [Google Scholar] [CrossRef]
- Albrich, W.C.; Rassouli, F.; Waldeck, F.; Berger, C.; Baty, F. Influence of Older Age and Other Risk Factors on Pneumonia Hospitalization in Switzerland in the Pneumococcal Vaccine Era. Front. Med. 2019, 6, 286. [Google Scholar] [CrossRef] [PubMed] [Green Version]
- Feikin, D.R.; Schuchat, A.; Kolczak, M.; Barrett, N.L.; Harrison, L.H.; Lefkowitz, L.; McGeer, A.; Farley, M.M.; Vugia, D.J.; Lexau, C.; et al. Mortality from invasive pneumococcal pneumonia in the era of antibiotic resistance, 1995–1997. Am. J. Public Health 2000, 90, 223–229. [Google Scholar] [PubMed] [Green Version]
- Huttner, B.; Cappello, B.; Cooke, G.; Gandra, S.; Harbarth, S.; Imi, M.; Loeb, M.; Mendelson, M.; Moja, L.; Pulcini, C.; et al. 2019 community-acquired pneumonia treatment guidelines: There is a need for a change toward more parsimonious antibiotic use. Am. J. Respir. Crit. Care Med. 2020, 201, 1315–1316. [Google Scholar] [CrossRef] [PubMed] [Green Version]
- Howell, A.B.; Reed, J.D.; Krueger, C.G.; Winterbottom, R.; Cunningham, D.G.; Leahy, M. A-type cranberry proanthocyanidins and uropathogenic bacterial anti-adhesion activity. Phytochemistry 2005, 66, 2281–2291. [Google Scholar] [CrossRef]
- Rane, H.S.; Bernardo, S.M.; Howell, A.B.; Lee, S.A. Cranberry-derived proanthocyanidins prevent formation of Candida albicans biofilms in artificial urine through biofilm- and adherence-specific mechanisms. J. Antimicrob. Chemother. 2014, 69, 428–436. [Google Scholar] [CrossRef] [PubMed] [Green Version]
- Pan, D.; Sze, S.; Martin, C.A.; Nevill, C.R.; Minhas, J.S.; Divall, P.; Nazareth, J.; Gray, L.J.; Khunti, K.; Abrams, K.R.; et al. COVID-19 and the new variant strain in England—What are the implications for those from ethnic minority groups? EClinicalMedicine 2021, 33, 100805. [Google Scholar] [CrossRef]
- Otto, S.P.; Day, T.; Arino, J.; Colijn, C.; Dushoff, J.; Li, M.; Mechai, S.; Van Domselaar, G.; Wu, J.; Earn, D.J.D.; et al. The origins and potential future of SARS-CoV-2 variants of concern in the evolving COVID-19 pandemic. Curr. Biol. 2021, 31, R918–R929. [Google Scholar] [CrossRef] [PubMed]
- Singh, D.; Yi, S. V On the origin and evolution of SARS-CoV-2. Exp. Mol. Med. 2021, 53, 537–547. [Google Scholar] [CrossRef] [PubMed]
- Sun, Z.; Ostrikov, K. (Ken) Future antiviral surfaces: Lessons from COVID-19 pandemic. Sustain. Mater. Technol. 2020, 25, e00203. [Google Scholar]
- Shirvanimoghaddam, K.; Akbari, M.K.; Yadav, R.; Al-Tamimi, A.K.; Naebe, M. Fight against COVID-19: The case of antiviral surfaces. APL Mater. 2021, 9, 31112. [Google Scholar] [CrossRef] [PubMed]
- Bhuvan, K.C.; Shrestha, R.; Leggat, P.A.; Ravi Shankar, P.; Shrestha, S. Safety of air travel during the ongoing COVID-19 pandemic. Travel Med. Infect. Dis. 2021, 43, 102103. [Google Scholar] [CrossRef]
- Mousavi, E.S.; Godri Pollitt, K.J.; Sherman, J.; Martinello, R.A. Performance analysis of portable HEPA filters and temporary plastic anterooms on the spread of surrogate coronavirus. Build. Environ. 2020, 183, 107186. [Google Scholar] [CrossRef]
- Ilyas, S.; Srivastava, R.R.; Kim, H. Disinfection technology and strategies for COVID-19 hospital and bio-medical waste management. Sci. Total Environ. 2020, 749, 141652. [Google Scholar] [CrossRef] [PubMed]
- MacIntyre, C.R.; Dung, T.C.; Chughtai, A.A.; Seale, H.; Rahman, B. Contamination and washing of cloth masks and risk of infection among hospital health workers in Vietnam: A post hoc analysis of a randomised controlled trial. BMJ Open 2020, 10, e042045. [Google Scholar] [CrossRef] [PubMed]
- Aragaw, T.A. Surgical face masks as a potential source for microplastic pollution in the COVID-19 scenario. Mar. Pollut. Bull. 2020, 159, 111517. [Google Scholar] [CrossRef]
- Rizan, C.; Reed, M.; Bhutta, M.F. Environmental impact of personal protective equipment distributed for use by health and social care services in England in the first six months of the COVID-19 pandemic. J. R. Soc. Med. 2021, 114, 250–263. [Google Scholar] [CrossRef]
- Hiemstra, A.-F.; Rambonnet, L.; Gravendeel, B.; Schilthuizen, M. The effects of COVID-19 litter on animal life. Anim. Biol. 2021, 71, 215–231. [Google Scholar] [CrossRef]
- Selvaranjan, K.; Navaratnam, S.; Rajeev, P.; Ravintherakumaran, N. Environmental challenges induced by extensive use of face masks during COVID-19: A review and potential solutions. Environ. Chall. 2021, 3, 100039. [Google Scholar] [CrossRef]
- Tuñón-Molina, A.; Cano-Vicent, A.; Martí, M.; Muramoto, Y.; Noda, T.; Takayama, K.; Serrano-Aroca, Á. Next generation infection prevention clothing: Non-woven Fabrics Coated with Cranberry Extracts Capable of Inactivating Enveloped Viruses such as SARS-CoV-2 and Multidrug-resistant Bacteria. bioRxiv 2021, 6, 23495–23503. [Google Scholar]
- Lotfi, M.; Hamblin, M.R.; Rezaei, N. COVID-19: Transmission, prevention, and potential therapeutic opportunities. Clin. Chim. Acta 2020, 508, 254–266. [Google Scholar] [CrossRef]
- De Georgeo, M.R.; De Georgeo, J.M.; Egan, T.M.; Klee, K.P.; Schwemm, M.S.; Bye-Kollbaum, H.; Kinser, A.J. Containing SARS-CoV-2 in hospitals facing finite PPE, limited testing, and physical space variability: Navigating resource constrained enhanced traffic control bundling. J. Microbiol. Immunol. Infect. 2020, 54, 4–11. [Google Scholar] [CrossRef] [PubMed]
- Arjunan, A.; Zahid, S.; Baroutaji, A.; Robinson, J. 3D printed auxetic nasopharyngeal swabs for COVID-19 sample collection. J. Mech. Behav. Biomed. Mater. 2020, 114, 104175. [Google Scholar] [CrossRef]
- Pradhan, D.; Biswasroy, P.; Kumar Naik, P.; Ghosh, G.; Rath, G. A Review of Current Interventions for COVID-19 Prevention. Arch. Med. Res. 2020, 51, 363–374. [Google Scholar] [CrossRef] [PubMed]
- Robinson, J.; Arjunan, A.; Baroutaji, A.; Martí, M.; Tuñón Molina, A.; Serrano-Aroca, Á.; Pollard, A. Additive manufacturing of anti-SARS-CoV-2 Copper-Tungsten-Silver alloy. Rapid Prototyp. J. 2021. ahead-of-print. [Google Scholar] [CrossRef]
- Vance, A.; Bari, K.; Arjunan, A. Compressive performance of an arbitrary stiffness matched anatomical Ti64 implant manufactured using Direct Metal Laser Sintering. Mater. Des. 2018, 160, 1281–1294. [Google Scholar] [CrossRef]
- Phillips, W.; Medcalf, N.; Dalgarno, K.; Makatsoris, H.; Sharples, S.; Srai, J.; Hourd, P.; Kapletia, D. Redistributed Manufacturing in Healthcare Creating New Value through Disruptive Innovation; UWE Bristol: Bristol, UK, 2018. [Google Scholar]
- Phillips, W.; Kapletia, D.; Dalgarno, K.; Hunt, P.; Bibb, R.; Makatsoris, H.; Rafiq, Q.; Roscoe, S.; Omar, B.; Willoughby, N.; et al. Innovation in healthcare manufacturing: Transforming Deployed Medical Care. In Proceedings of the The ISPIM Innovation Conference—Innovating Our Common Future, Berlin, Germany, 23–28 June 2020; Loughborough University: Berlin, Germany, 2020. [Google Scholar]
- Cano-Vicent, A.; Tambuwala, M.M.; Hassan, S.S.; Barh, D.; Aljabali, A.A.A.; Birkett, M.; Arjunan, A.; Serrano-Aroca, Á. Fused deposition modelling: Current status, methodology, applications and future prospects. Addit. Manuf. 2021, 47, 102378. [Google Scholar] [CrossRef]
- Radfar, P.; Bazaz, S.R.; Mirakhorli, F.; Warkiani, M.E. The role of 3D printing in the fight against COVID-19 outbreak. J. 3D Print. Med. 2021, 5, 51–60. [Google Scholar] [CrossRef]
- Longhitano, G.A.; Nunes, G.B.; Candido, G.; da Silva, J.V.L. The role of 3D printing during COVID-19 pandemic: A review. Prog. Addit. Manuf. 2020, 6, 1–19. [Google Scholar] [CrossRef]
- Vakharia, V.N.; Khan, S.; Marathe, K.; Giannis, T.; Webber, L.; Choi, D. Printing in a Pandemic: 3D printing solutions for healthcare during COVID-19. A Protocol for a PRISMA systematic review. Ann. 3D Print. Med. 2021, 2, 100015. [Google Scholar] [CrossRef]
- Jeyachandran, P.; Bontha, S.; Bodhak, S.; Balla, V.K.; Kundu, B.; Doddamani, M. Mechanical behaviour of additively manufactured bioactive glass/high density polyethylene composites. J. Mech. Behav. Biomed. Mater. 2020, 108, 103830. [Google Scholar] [CrossRef] [PubMed]
- Zanocco, M.; Boschetto, F.; Zhu, W.; Marin, E.; McEntire, B.J.; Bal, B.S.; Adachi, T.; Yamamoto, T.; Kanamura, N.; Ohgitani, E.; et al. 3D-additive deposition of an antibacterial and osteogenic silicon nitride coating on orthopaedic titanium substrate. J. Mech. Behav. Biomed. Mater. 2020, 103, 103557. [Google Scholar] [CrossRef] [PubMed]
- Calignano, F. Investigation of the accuracy and roughness in the laser powder bed fusion process. Virtual Phys. Prototyp. 2018, 13, 97–104. [Google Scholar] [CrossRef]
- van Doremalen, N.; Bushmaker, T.; Morris, D.H.; Holbrook, M.G.; Gamble, A.; Williamson, B.N.; Tamin, A.; Harcourt, J.L.; Thornburg, N.J.; Gerber, S.I.; et al. Aerosol and Surface Stability of SARS-CoV-2 as Compared with SARS-CoV-1. N. Engl. J. Med. 2020, 382, 1564–1567. [Google Scholar] [CrossRef]
- Dev Kumar, G.; Mishra, A.; Dunn, L.; Townsend, A.; Oguadinma, I.C.; Bright, K.R.; Gerba, C.P. Biocides and Novel Antimicrobial Agents for the Mitigation of Coronaviruses. Front. Microbiol. 2020, 11, 1351. [Google Scholar] [CrossRef]
- Cortes, A.A.; Zuñiga, J.M. The use of copper to help prevent transmission of SARS-Coronavirus and Influenza viruses. A general Review. Diagn. Microbiol. Infect. Dis. 2020, 98, 115176. [Google Scholar] [CrossRef]
- Pullangott, G.; Kannan, U.; Gayathri, S.; Kiran, D.V.; Maliyekkal, S.M. A comprehensive review on antimicrobial face masks: An emerging weapon in fighting pandemics. RSC Adv. 2021, 11, 6544–6576. [Google Scholar] [CrossRef]
- Duan, S.-M.; Zhao, X.-S.; Wen, R.-F.; Huang, J.-J.; Pi, G.-H.; Zhang, S.-X.; Han, J.; Bi, S.-L.; Ruan, L.; Dong, X.-P. Stability of SARS coronavirus in human specimens and environment and its sensitivity to heating and UV irradiation. Biomed. Environ. Sci. 2003, 16, 246–255. [Google Scholar] [PubMed]
- Chan, K.H.; Peiris, J.S.M.; Lam, S.Y.; Poon, L.L.M.; Yuen, K.Y.; Seto, W.H. The effects of temperature and relative humidity on the viability of the SARS coronavirus. Adv. Virol. 2011, 2011, 734690. [Google Scholar] [CrossRef] [PubMed]
- Rabenau, H.F.; Cinatl, J.; Morgenstern, B.; Bauer, G.; Preiser, W.; Doerr, H.W. Stability and inactivation of SARS coronavirus. Med. Microbiol. Immunol. 2005, 194, 1–6. [Google Scholar] [CrossRef] [Green Version]
- Lai, M.Y.Y.; Cheng, P.K.C.; Lim, W.W.L. Survival of Severe Acute Respiratory Syndrome Coronavirus. Clin. Infect. Dis. 2005, 41, e67–e71. [Google Scholar] [CrossRef] [PubMed] [Green Version]
- Kampf, G.; Todt, D.; Pfaender, S.; Steinmann, E. Persistence of coronaviruses on inanimate surfaces and their inactivation with biocidal agents. J. Hosp. Infect. 2020, 104, 246–251. [Google Scholar] [CrossRef] [Green Version]
- Aydogdu, M.O.; Altun, E.; Chung, E.; Ren, G.; Homer-Vanniasinkam, S.; Chen, B.; Edirisinghe, M. Surface interactions and viability of coronaviruses. J. R. Soc. Interface 2021, 18, 20200798. [Google Scholar] [CrossRef] [PubMed]
- Shidham, V.B.; Frisch, N.K.; Layfield, L.J. Severe acute respiratory syndrome coronavirus 2 (the cause of COVID 19) in different types of clinical specimens and implications for cytopathology specimen: An editorial review with recommendations. Cytojournal 2020, 17, 7. [Google Scholar] [CrossRef]
- Hutasoit, N.; Kennedy, B.; Hamilton, S.; Luttick, A.; Rahman Rashid, R.A.; Palanisamy, S. Sars-CoV-2 (COVID-19) inactivation capability of copper-coated touch surface fabricated by cold-spray technology. Manuf. Lett. 2020, 25, 93–97. [Google Scholar] [CrossRef]
- Balagna, C.; Perero, S.; Percivalle, E.; Nepita, E.V.; Ferraris, M. Virucidal effect against coronavirus SARS-CoV-2 of a silver nanocluster/silica composite sputtered coating. Open Ceram. 2020, 1, 100006. [Google Scholar] [CrossRef]
- Bradley, D. Copper against Covid. Mater. Today 2020, xx, 7021. [Google Scholar] [CrossRef]
- Hatamie, S.; Nouri, M.; Karandikar, S.K.; Kulkarni, A.; Dhole, S.D.; Phase, D.M.; Kale, S.N. Complexes of cobalt nanoparticles and polyfunctional curcumin as antimicrobial agents. Mater. Sci. Eng. C 2012, 32, 92–97. [Google Scholar] [CrossRef]
- Chang, E.L.; Simmers, C.; Knight, D.A. Cobalt Complexes as Antiviral and Antibacterial Agents. Pharmaceuticals 2010, 3, 1711–1728. [Google Scholar] [CrossRef] [Green Version]
- Watanabe, K.; Fukuzaki, S.; Sugino, A.; Benson, N.; Metcalf, N.; Nakamura, M.; Matsumoto, M. Cobalt-Chromium Alloy has Superior Antibacterial Effect than Titanium Alloy: In Vitro: And: In Vivo: Studies. Spine 2021, 46, E911. [Google Scholar] [CrossRef]
- Zhukov, A.S.; Barakhtin, B.K.; Kamynin, A.V.; Gavrikov, I.S.; Kuznetsov, P.A. Features of structure-sensitive hard magnetic alloy Fe—25 wt. % Cr—15 wt. % Co manufactured by Laser Powder Bed Fusion. Procedia CIRP 2020, 94, 243–247. [Google Scholar] [CrossRef]
- Santecchia, E.; Gatto, A.; Bassoli, E.; Denti, L.; Rutkowski, B.; Mengucci, P.; Barucca, G. Precipitates formation and evolution in a Co-based alloy produced by powder bed fusion. J. Alloys Compd. 2019, 797, 652–658. [Google Scholar] [CrossRef]
- Priya, P.; Mercer, B.; Huang, S.; Aboukhatwa, M.; Yuan, L.; Chaudhuri, S. Towards prediction of microstructure during laser based additive manufacturing process of Co-Cr-Mo powder beds. Mater. Des. 2020, 196, 109117. [Google Scholar] [CrossRef]
- Young, Z.A.; Guo, Q.; Parab, N.D.; Zhao, C.; Qu, M.; Escano, L.I.; Fezzaa, K.; Everhart, W.; Sun, T.; Chen, L. Types of spatter and their features and formation mechanisms in laser powder bed fusion additive manufacturing process. Addit. Manuf. 2020, 36, 101438. [Google Scholar] [CrossRef]
- Konieczny, B.; Szczesio-Wlodarczyk, A.; Sokolowski, J.; Bociong, K. Challenges of Co-Cr Alloy Additive Manufacturing Methods in Dentistry-The Current State of Knowledge (Systematic Review). Materials 2020, 13, 3524. [Google Scholar] [CrossRef]
- Mukherjee, T.; DebRoy, T. Mitigation of lack of fusion defects in powder bed fusion additive manufacturing. J. Manuf. Process. 2018, 36, 442–449. [Google Scholar] [CrossRef]
- Darvish, K.; Chen, Z.W.; Pasang, T. Reducing lack of fusion during selective laser melting of CoCrMo alloy: Effect of laser power on geometrical features of tracks. Mater. Des. 2016, 112, 357–366. [Google Scholar] [CrossRef]
- Arjunan, A.; Singh, M.; Baroutaji, A.; Wang, C. Additively manufactured AlSi10Mg inherently stable thin and thick-walled lattice with negative Poisson’s ratio. Compos. Struct. 2020, 247, 112469. [Google Scholar] [CrossRef]
- Yadroitsev, I.; Yadroitsava, I.; Du Plessis, A.; MacDonald, E. (Eds.) Fundamentals of Laser Powder Bed Fusion of Metals, 1st ed.; Elsevier: Amsterdam, The Netherlands, 2021; ISBN 9780128240908. [Google Scholar]
- Khairallah, S.A.; Anderson, A.T.; Rubenchik, A.; King, W.E. Laser powder-bed fusion additive manufacturing: Physics of complex melt flow and formation mechanisms of pores, spatter, and denudation zones. Acta Mater. 2016, 108, 36–45. [Google Scholar] [CrossRef] [Green Version]
- Zhang, T.; Li, H.; Liu, S.; Shen, S.; Xie, H.; Shi, W.; Zhang, G.; Shen, B.; Chen, L.; Xiao, B.; et al. Evolution of molten pool during selective laser melting of Ti-6Al-4V. J. Phys. D. Appl. Phys. 2018, 52, 55302. [Google Scholar] [CrossRef]
- Sun, Z.; Tan, X.; Tor, S.B.; Yeong, W.Y. Selective laser melting of stainless steel 316L with low porosity and high build rates. Mater. Des. 2016, 104, 197–204. [Google Scholar] [CrossRef]
- Tucho, W.M.; Lysne, V.H.; Austbø, H.; Sjolyst-Kverneland, A.; Hansen, V. Investigation of effects of process parameters on microstructure and hardness of SLM manufactured SS316L. J. Alloys Compd. 2018, 740, 910–925. [Google Scholar] [CrossRef]
- Song, C.; Zhang, M.; Yang, Y.; Wang, D.; Jia-kuo, Y. Morphology and properties of CoCrMo parts fabricated by selective laser melting. Mater. Sci. Eng. A 2018, 713, 206–213. [Google Scholar] [CrossRef]
- Bayat, M.; Thanki, A.; Mohanty, S.; Witvrouw, A.; Yang, S.; Thorborg, J.; Skat Tiedje, N.; Hattel, J.H. Keyhole-induced porosities in Laser-based Powder Bed Fusion (L-PBF) of Ti6Al4V: High-fidelity modelling and experimental validation. Addit. Manuf. 2019, 30, 100835. [Google Scholar] [CrossRef]
- King, W.E.; Barth, H.D.; Castillo, V.M.; Gallegos, G.F.; Gibbs, J.W.; Hahn, D.E.; Kamath, C.; Rubenchik, A.M. Observation of keyhole-mode laser melting in laser powder-bed fusion additive manufacturing. J. Mater. Process. Technol. 2014, 214, 2915–2925. [Google Scholar] [CrossRef]
- Robinson, J.; Arjunan, A.; Stanford, M.; Lyall, I.; Williams, C. Effect of silver addition in copper-silver alloys fabricated by laser powder bed fusion in situ alloying. J. Alloys Compd. 2021, 857, 157561. [Google Scholar] [CrossRef]
- Bryant, C.; Wilks, S.A.; Keevil, C.W. Rapid inactivation of SARS-CoV-2 on copper touch surfaces determined using a cell culture infectivity assay. bioRxiv 2021. [Google Scholar] [CrossRef]
- Arjunan, A.; Robinson, J.; Al Ani, E.; Heaselgrave, W.; Baroutaji, A.; Wang, C. Mechanical performance of additively manufactured pure silver antibacterial bone scaffolds. J. Mech. Behav. Biomed. Mater. 2020, 112, 104090. [Google Scholar] [CrossRef]
- Kitajima, M.; Ahmed, W.; Bibby, K.; Carducci, A.; Gerba, C.P.; Hamilton, K.A.; Haramoto, E.; Rose, J.B. SARS-CoV-2 in wastewater: State of the knowledge and research needs. Sci. Total Environ. 2020, 739, 139076. [Google Scholar] [CrossRef]
- Fedorenko, A.; Grinberg, M.; Orevi, T.; Kashtan, N. Survival of the enveloped bacteriophage Phi6 (a surrogate for SARS-CoV-2) in evaporated saliva microdroplets deposited on glass surfaces. Sci. Rep. 2020, 10, 1–10. [Google Scholar] [CrossRef]

| Material | Duration | Ref. |
|---|---|---|
| Aerosol | 1.2 h | Doremalen et al. [71] |
| Glass | 4 days | Duan et al. [75] |
| Plastic | <5 days | Chan et al. [76] |
| PVC | 4–9 days | Duan et al. [75] and Rabenau et al. [77] |
| Paper | 1-5 days | Lai et al. [78] and Duan et al. [75] |
| Steel | 3 days | Doremalen et al. [71] |
| Wood | 4–5 days | Duan et al. [75] and Kampf et al. [79] |
| Ceramics | 5 days | Aydogdu et al. [80] |
| Silicon rubber | 5 days | Shidham et al. [81] and Aydogdu et al. [80] |
| Copper | 4–5 h | Hutasoit et al. [82] and Doremalen et al. [71] |
| Silver | 4–5 h | Kumar et al. [72] and Balagna et al. [83] |
| Variable Factors | Responses (µm) | |||
|---|---|---|---|---|
| 0.60 | 900 | 85 | 97 | 502 |
| 0.37 | 900 | 110 | 118 | 262 |
| 0.37 | 1025 | 135 | 111 | 272 |
| 0.37 | 900 | 110 | 118 | 262 |
| 0.37 | 900 | 110 | 118 | 262 |
| 0.14 | 900 | 85 | 97 | 62 |
| 0.37 | 1025 | 85 | 94 | 264 |
| 0.60 | 900 | 135 | 128 | 479 |
| 0.37 | 775 | 85 | 99 | 275 |
| 0.60 | 775 | 110 | 113 | 474 |
| 0.60 | 1025 | 110 | 78 | 494 |
| 0.37 | 900 | 110 | 118 | 262 |
| 0.37 | 900 | 110 | 118 | 262 |
| 0.14 | 1025 | 110 | 78 | 65 |
| 0.14 | 775 | 110 | 113 | 53 |
| 0.37 | 775 | 135 | 136 | 251 |
| Model | F-Value | p-Value | Statistical Measurements | ||
|---|---|---|---|---|---|
| R2 | Adj-R2 | Adeq-Precision | |||
| 12.60 | 0.003 | 0.9498 | 0.8744 | 12.7989 | |
| 1602.67 | <0.0001 | 0.9975 | 0.9969 | 108.7482 | |
| Number | Desirability | |||
|---|---|---|---|---|
| 1 | 0.14 | 1025 | 88 | 0.98 |
| Item | ||
|---|---|---|
| Predicted | 78 | 63 |
| Actual | 75 | 61 |
| Difference (%) | 3.9% | 3.2% |
| Identifier | Material | Antiviral Activity | |||
|---|---|---|---|---|---|
| 30 min | 5 h | ||||
| Log | % | Log | % | ||
| #1 | Control | 0 | 0% | 0 | 0% |
| #2 | Porous fabric | 0 | 0.1% | 0 | 2.8% |
| #3 | Co-Cr-Mo | −6 | 100% | −6 | 100% |
| Hutasoit et al. [82] | Cu | −0.4 | 0% | −2.2 | 99.2% |
| Elements | Co | Cr | Mo | Si | Mn | Fe | C | Ni |
|---|---|---|---|---|---|---|---|---|
| Composition (wt. %) |
| Variables | Description | Units | Codes | Min. | Med. | Max. |
|---|---|---|---|---|---|---|
| Hatch spacing | A | 0.14 | 0.37 | 0.60 | ||
| Scanning rate | B | 775 | 900 | 1025 | ||
| Laser power | C | 85 | 110 | 135 |
Publisher’s Note: MDPI stays neutral with regard to jurisdictional claims in published maps and institutional affiliations. |
© 2021 by the authors. Licensee MDPI, Basel, Switzerland. This article is an open access article distributed under the terms and conditions of the Creative Commons Attribution (CC BY) license (https://creativecommons.org/licenses/by/4.0/).
Share and Cite
Arjunan, A.; Robinson, J.; Baroutaji, A.; Tuñón-Molina, A.; Martí, M.; Serrano-Aroca, Á. 3D Printed Cobalt-Chromium-Molybdenum Porous Superalloy with Superior Antiviral Activity. Int. J. Mol. Sci. 2021, 22, 12721. https://doi.org/10.3390/ijms222312721
Arjunan A, Robinson J, Baroutaji A, Tuñón-Molina A, Martí M, Serrano-Aroca Á. 3D Printed Cobalt-Chromium-Molybdenum Porous Superalloy with Superior Antiviral Activity. International Journal of Molecular Sciences. 2021; 22(23):12721. https://doi.org/10.3390/ijms222312721
Chicago/Turabian StyleArjunan, Arun, John Robinson, Ahmad Baroutaji, Alberto Tuñón-Molina, Miguel Martí, and Ángel Serrano-Aroca. 2021. "3D Printed Cobalt-Chromium-Molybdenum Porous Superalloy with Superior Antiviral Activity" International Journal of Molecular Sciences 22, no. 23: 12721. https://doi.org/10.3390/ijms222312721
APA StyleArjunan, A., Robinson, J., Baroutaji, A., Tuñón-Molina, A., Martí, M., & Serrano-Aroca, Á. (2021). 3D Printed Cobalt-Chromium-Molybdenum Porous Superalloy with Superior Antiviral Activity. International Journal of Molecular Sciences, 22(23), 12721. https://doi.org/10.3390/ijms222312721

